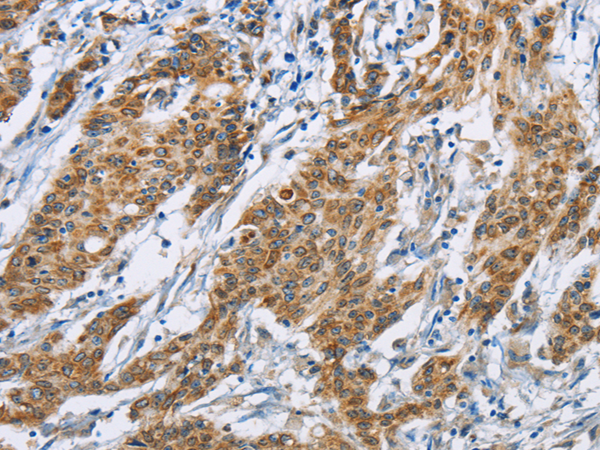

-
分类: 科研抗体货号: P08132别名: p67; SIGLEC3; SIGLEC-3应用: WB,IHC反应种属: Human, Mouse
-
分类: 科研抗体货号: P08111别名: CACRC应用: WB反应种属: Human, Mouse
-
分类: 科研抗体货号: P08091别名: CALB应用: WB,IHC反应种属: Human, Mouse, Rat
-
分类: 科研抗体货号: P08131别名: CD329; CDw329; FOAP-9; siglec-9; OBBP-LIKE应用: WB,IHC反应种属: Human
-
分类: 科研抗体货号: P08110别名:应用: IHC反应种属: Human
-
分类: 科研抗体货号: P08130别名: BTLA1; CD272应用: WB,IHC反应种属: Human
-
分类: 科研抗体货号: P08090别名: BIgR; NECL1; TSLL1; IGSF4B; Necl-1; synCAM3应用: IHC反应种属: Human, Mouse, Rat
-
分类: 科研抗体货号: P08109别名: SPGF7; CATSPER应用: IHC反应种属: Human
-
分类: 科研抗体货号: P08125别名: OX2R; MOX2R; CD200R; HCRTR2应用: IHC反应种属: Human
-
分类: 科研抗体货号: P08108别名:应用: WB,IHC反应种属: Human, Mouse, Rat

鄂公网安备42018502007531号
鄂公网安备42018502007531号

